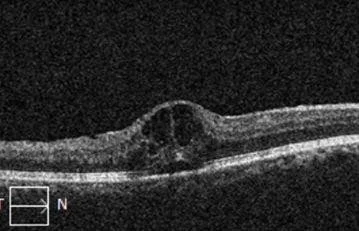

Retinal vein occlusion
Central retinal vein occlusion
Branch retinal vein occlusion
What is the retina?
If the eye were a camera, the retina would be the film of that camera
The retina is a thin sheet of nerve cells that lines the inside back wall of the eye
Light travels through the eye and ultimately reaches photoreceptors, the light-sensitive cells in the retina
The signal from the photoreceptors then travel along the optic nerve to the brain, where the signals are interpreted as vision
What is a retinal vein occlusion?
Arteries supply blood TO the retina
Veins drain blood FROM the retina
A blockage in a retinal vein results in a retinal vein occlusion
Central retinal vein occlusion involves blockage of the central retinal vein (the main vein draining blood from the retina) that drains blood from the entire retina
Branch retinal vein occlusion involves blockage of any one of the smaller veins draining a portion of the retina
A retinal vein occlusion is not the same thing as a stroke
What causes retinal vein occlusion?
Risk factors for retinal vein occlusion include:
age
elevated blood pressure
elevated or abnormal cholesterol levels
elevated blood glucose levels or diabetes
glaucoma or elevated eye pressure
conditions that predispose an individual to blood clots
Thus all patients with retinal vein occlusion should see the primary care provider to optimize glucose, cholesterol, and blood pressure, and some patients may require additional testing.
Normal retina for reference
Central retinal vein occlusion. Due to blockage of the central retinal vein, pressure builds up in the vascular system resulting in disruption in blood flow, hemorrhage from the veins, and retinal swelling.
How might a retinal vein occlusion affect my vision?
Disruption or loss of blood flow to the retina
There is no treatment for this aspect of retinal vein occlusion
Cystoid macular edema (CME)
Edema means “swelling”
Blood vessels damaged from the vein occlusion are leaky, and the fluid that leaks from these vessels accumulate in the retina
The macula is the centermost part of the retina, which is responsible for much of high quality vision
Swelling (edema) in the retina results in vision loss
There are very effective treatments for macular edema from retinal vein occlusion
Neovascularization
When the eye loses blood flow, it may respond by creating abnormal “new blood vessels” (neovascularization)
Neovascular blood vessels can impact the vision by:
Vitreous hemorrhage
Bleeding into the eye
Instead of being filled with clear fluid through which one can see, the back of the eye is filled with blood, causing vision loss
Tractional retinal detachment
The new blood vessels pull on the retina (create “traction”) and pull the retina off the eye wall (“retinal detachment”)
The photoreceptors in detached retina cannot see and undergo damage, resulting in severe vision loss, sometimes irreversible vision loss
Glaucoma
If the abnormal blood vessels form in in the front of the eye, they can result in glaucoma, which involves elevated eye pressure and if untreated, vision loss
Optical coherence tomography (OCT) images showing macular edema in a patient with retinal vein occlusion.
What kind of tests will be performed to evaluate a retinal vein occlusion?
Dilated retinal examination
Optical coherence tomography (a scan to look for swelling in the retina (DME))
Top image: An optical coherence tomography (OCT) scan is a safe and painless imaging test that allows for examination of microscopic changes in the retina. Bottom left image: Right eye retina. Left image: OCT-scan through a single slice of the retina shown in the left image. The OCT is normal. The downward dip in the retina is the normal foveal depression.
In some patients:
Fluorescein angiography
A dye is injected into the arm, from which to travels through the blood to the eye.
Photographs are taken of the eye which map out all the blood vessels and blood flow in the retina
This test identifies areas of blood flow loss as well as areas of new blood vessel grown (neovascularization)
B-scan ultrasound
Painless procedure whereby an ultrasound is performed over the closed eyelid to evaluate the retinal anatomy in eyes where hemorrhage prevents visualization of retinal details through the eye exam alone
How is macular edema from a retinal vein occlusion treated?
Intravitreal injections
These medications are injected into the eye after drops are given to numb the eye
Injections are given in the office. The drops are given over 5-10 minutes to clean and numb the eye, and the injection itself takes only seconds
There are 2 types of medications that can be used
Anti-vascular endothelial growth factor (anti-VEGF) injections
Names: Avastin (bevacizumab), Lucentis (ranibizumab), Eylea (aflibercept), Vabysmo (faricimab), and others.
A substance called VEGF causes the retinal blood vessels to be leaky and in turm cause edema. These drugs block VEGF. Vabysmo works by blocking not only VEGF, but also Ang2, another molecule that is involved in diabetic retinopathy.
Steroids
Names: Triessence (triamcinolone), Ozurdex implant (dexamethasone, lasts several months)
Inflammation contributes to leaky blood vessels that cause edema. Steroids reduce inflammation.
How is neovascularization from retinal vein occlusion treated?
Laser (in the office)
If there is edema present, the injections used to treat the edema can also improve the neovascularization
If there is vitreous hemorrhage or tractional retinal detachment, surgery may be necessary (see below)
How is vitreous hemorrhage from retinal vein occlusion treated?
Observation / medical management
Vitreous hemorrhage may resolve on its own, and thus may be monitored
After the hemorrhage resolves, laser may be performed (laser cannot be performed through hemorrhage)
If the hemorrhage fails to clear or other complications are noted, surgery may be indicated
Surgery
Pars plana vitrectomy surgery
The hemorrhage is removed, the traction from the new blood vessel (neovascularization) membranes is relieved, and laser is applied to allow the neovascularization to regress
An injection of anti-VEGF medication may be given prior to surgery to reduce intraoperative and postoperative complications risk